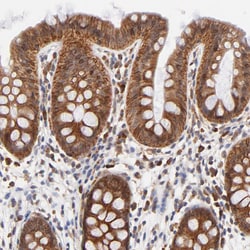
Invitrogen TXNL1 Polyclonal Antibody 100 &mu;L; Unconjugated:Antibodies,

Learn More
Invitrogen™ TXNL1 Polyclonal Antibody


Rabbit Polyclonal Antibody
Brand: Invitrogen™ PA551748
Description
Immunogen sequence: CLNESDEHGF DNCLRKDTTF LESDCDEQLL ITVAFNQPVK LYSMKFQGPD NGQGPKYVKI FINLPRSMDF EEAERSEPTQ ALELTEDDIK EDGIVPLRYV KFQNVNSVTI FVQSNQGEEE TTRISYFTFI GTPVQATNMN DFKRVVGK Highest antigen sequence identity to the following orthologs: Mouse - 98%, Rat - 98%.
Thioredoxins are a group of small redox active proteins possessing a conserved active site sequence. TrxL (Thioredoxin like protein 1) has 2 distinct domains: an N terminal domain, which is 43% identical to human TXN, and a C terminal domain, which shows no homology to other proteins in the sequence databases. The active site sequence, located within the N terminal domain, is that of a thioredoxin like protein; compared to the active site sequence of TXN, it has a single amino acid substitution. Unlike other thioredoxin like proteins, TrxL does not serve as a substrate for thioredoxin reductase in an insulin assay.
Specifications
| TXNL1 | |
| Polyclonal | |
| Unconjugated | |
| Txnl1 | |
| 32 kDa thioredoxin-related protein; 32kDa; epididymis secretory protein Li 114; HEL-S-114; thioredoxin like 1; thioredoxin-like (32kD); thioredoxin-like 1; thioredoxin-like protein 1; thioredoxin-related 32 kDa protein; thioredoxin-related protein; thioredoxin-related protein 1; Trp; TRP32; TXL; TXL-1; Txnl; TXNL1 | |
| Rabbit | |
| Antigen affinity chromatography | |
| RUO | |
| 140922, 53382, 9352 | |
| Store at 4°C short term. For long term storage, store at -20°C, avoiding freeze/thaw cycles. | |
| Liquid |
| Immunohistochemistry (Paraffin), Western Blot, Immunocytochemistry | |
| 0.05 mg/mL | |
| PBS with 40% glycerol and 0.02% sodium azide; pH 7.2 | |
| O43396, Q8CDN6, Q920J4 | |
| Txnl1 | |
| Recombinant protein corresponding to Human TXNL1. Recombinant protein control fragment (Product #RP-101856). | |
| 100 μL | |
| Primary | |
| Human, Mouse, Rat | |
| Antibody | |
| IgG |
Your input is important to us. Please complete this form to provide feedback related to the content on this product.